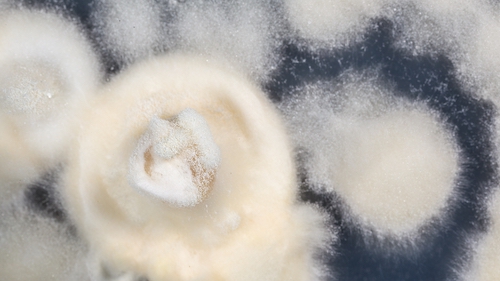
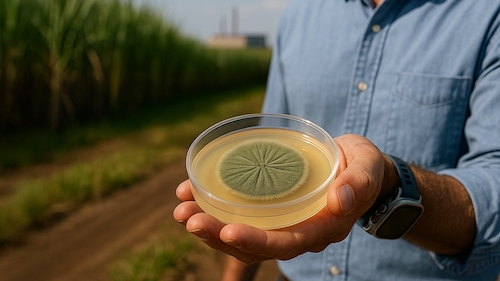

Bioinsumos: Falta de refrigeração compromete eficiência no campo
Sob falsa promessa de “economia” e “tecnologia de ponta”, a negligência com soluções biológicas gera prejuízos na lavoura e no bolso do produtor
O uso de bioinsumos no Brasil tem mostrado um crescimento significativo nas últimas décadas, especialmente na safra 2024/2025. O uso de soluções biológicas no campo cresceu 13% em comparação à safra anterior, com uma área potencial tratada de 156 milhões de hectares, de acordo com levantamento da Blink/CropLife Brasil.
Porém, junto com o crescimento do setor, surgem mitos que podem comprometer a rentabilidade do agricultor, dentre eles – e um dos mais perigosos – a ideia de que produtos biológicos dispensam refrigeração.

A negligência com o controle térmico pode custar caro no campo, explica o Diretor Industrial da Koppert América do Sul, Danilo Pedrazzoli:
“Os produtos biológicos são organismos vivos, e como todo ser vivo, precisam de condições adequadas para manter sua viabilidade até o momento da aplicação. Sem o controle de temperatura, esses microrganismos e macrorganismos perdem potência, têm sua vida útil reduzida e, consequentemente, deixam de entregar os resultados esperados”, diz.
Como exemplo, Pedrazzoli cita os produtos à base de fungos entomopatogênicos registrados em especificações de referência, como o Metarhizium e o Beauveria, que obrigatoriamente precisam da cadeia de frio para garantir qualidade e shelf-life. “Porém, muitos players de mercado, por não possuírem estrutura adequada e pelo impacto do custo, oferecem os produtos ‘simplificando’ a venda, e quem realmente perde é o setor e, principalmente, o produtor”, acrescenta.
A refrigeração é parte importante do processo e, por isso, indispensável para preservar a estabilidade e a eficácia dos bioinsumos, desde a produção, passando pelo transporte e armazenamento, até o momento da aplicação no cultivo.
Falsas promessas
Facilidade logística e redução de custos são afirmações usadas para mascarar a falta do controle de temperatura em produtos biológicos destinados ao manejo de pragas. Uma escolha enganosa que gera prejuízos reais no plantio.
Isso porque, quando o processo é negligenciado no armazenamento, por exemplo, os organismos vivos podem perder sua capacidade de eliminar a praga ou mesmo morrer, comprometendo os resultados esperados no cultivo, independentemente da cultura onde será aplicada.
“Cada formulação biológica possui sua temperatura ideal de conservação. Para que os agentes biológicos possam atuar da forma que se espera, seja em uma aplicação radicular, foliar ou em sementes, as recomendações de temperatura devem ser seguidas, do contrário, não se pode esperar uma atuação eficiente”, observa Pedrazzoli.
Consequências no campo
No caso das soluções microbiológicas à base de fungos, bacilos e nematoides, a virulência é mantida apenas quando conservadas em temperatura ideal. Fora dessas condições, o tempo de vida útil desses patógenos diminui e o rendimento da aplicação é perdida.
Quanto às macrobiológicas, o controle térmico garante que os parasitoides permaneçam viáveis e emerjam no tempo certo (no caso de formulações com ovos parasitados), agindo com máxima energia na plantação. Quando esse controle não é feito, o risco de predação aumenta, a longevidade e fecundidade do agente biológico são afetados, bem como sua ação no campo.
Em ambos os casos, o agricultor que acredita estar economizando ao não adotar refrigeração, na prática, está comprometendo a eficácia do produto e aumentando o risco de perdas de produtividade. Resultado? Prejuízos não apenas na lavoura, mas também no bolso.
“A natureza exige cuidados. Sem refrigeração, o agricultor perde eficiência, arruína a produtividade e, consequentemente, a colheita”, reforça Pedrazzoli. “Nosso compromisso não é com promessas, mas com resultados concretos no campo”, acrescenta.
Ciência com resultados
Na Koppert, a refrigeração é integrada à cadeia de produção, armazenamento, logística e aplicação. Cada formulação tem sua temperatura ideal, indicada no rótulo e reforçada por especialistas e consultores em campo, junto aos produtores. Um cuidado que garante a integridade de seus produtos até o destino final.
A empresa, que tem sede na cidade de Piracicaba (SP), é líder global no desenvolvimento e fornecimento de soluções biológicas para a agricultura. Há mais de cinco décadas, a Koppert transforma ciência em tecnologia viva, oferecendo produtos que aliam sustentabilidade, inovação e eficiência comprovada, apoiando produtores no Brasil e em mais de 100 países.
Quem entende de biológico, entende de refrigeração. Biológico é Koppert!






